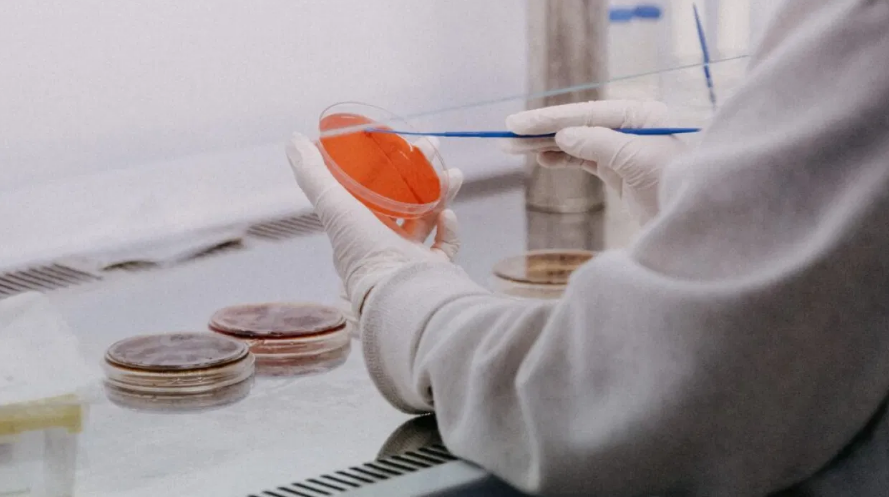

Médicos alertan sobre extraño síndrome en niños relacionado con COVID-19
Autoridades sanitarias de los Estados Unidos han alertado sobre el aumento significativo del síndrome inflamatorio multisistémico en niños. Esta rara condición ha demostrado estar relacionada con el COVID-19. Muchos menores enfermos con este padecimiento han requerido cuidados intensivos.
Según la guía publicada por el Centro de Control de Enfermedades de los Estados Unidos (CDC, por sus siglas en inglés), el síndrome inflamatorio multisitémico en niños (conocido en inglés como MIS-C) es una extraña condición donde diferentes órganos del cuerpo se inflaman con resultados severos. Entre los órganos afectados se encuentran la piel, ojos, riñones, pulmones, intestinos y el corazón.
Los niños con este síndrome relacionado al COVID-19 han presentado fiebre que, por lo general, se acompaña de síntomas como la diarrea, el dolor de cuello, sarpullido, fatiga extrema, vómito y dolor ambdominal.
“Hay alrededor de dos mil niños y adolescentes que han desarrollado este síndrome inflamatorio muy severo, que los puede llevar a terapia intensiva, que les lastima órganos como los pulmones o los riñones”, explicó el científico Antonio Lazcano en entrevista con Denise Maerker.
Algunos de estos menores desarrollan un síndrome que los médicos han bautizado como “Covid largo”. Dicho padecimiento se caracteriza por somnolencia, pérdida de apetito y una fatiga crónica. Otros han tenido que enfrentar consecuencias aún más graves como amputaciones de extremidades y daños en el corazón y riñones.
La mayoría de estos casos se ha presentado en menores entre los 3 y los 12 años de edad, aunque también hay casos registrados en adolescentes. En Estados Unidos, donde la cifra total de fallecimientos rebasa el medio millón de personas, han fallecido cerca de 250 niños por complicaciones derivadas del COVID-19.